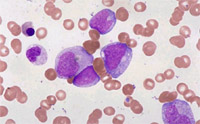
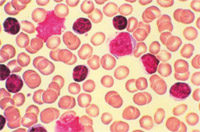

Obsah:
- O leukemii
- Diagnostika
- Léčba
Leukemie není jedním onemocněním. Jde o skupinu nemocí s různou prognózou, které se projevují poruchou funkce kostní dřeně a krve. V podstatě jde o zhoubný nádor (někdy se nepříliš přesně uvádí, že jde o rakovinu) bílých krvinek, tedy jedné ze složek imunitního systému člověka.
Slovo leukemie, které lze do češtiny přeložit jako "bílá krev" nebo "bělokrevnost", vymyslel významný německý patolog Rudolf Virchow (obrázek 1) v polovině 19. století, jenž jako jeden z prvních lékařů toto onemocnění rozpoznal.
![]() Obrázek 1. Rudolf Virchow (1821 - 1902), muž, jenž jako první použil slovo "leukemie", "bílá krev" |
Slovo leukemie je pro většinu lidí synonymem něčeho hrozného, odstrašujícího, synonymem rychlé a neodvratné smrti. Hodně se o leukemiích mluví, i když zdaleka nejsou nejčastějšími nemocemi. Ročně je v České republice zjištěno kolem 1100 nových případů leukemií. Daleko více je onemocnění srdce a cév, daleko více je vážných úrazů. A navíc ani zdaleka ne všechny leukemie vyžadují léčbu, nebo pokud je nutné je léčit, pak se je, díky stále se lepšícím možnostem, léčit daří a nemocní se vrací do plnohodnotného života.
Stručná historie nemoci
Leukemii si jako první nezávisle na sobě povšimli Francouz Alfred Donné, Skoti John Hughes Bennet a David Craigie a Němec Rudolf Virchow. Tito lékaři nemoc pozorovali již před rokem 1850. Je ale nepravděpodobné, že by se nemoc poprvé objevila až nedlouho před rokem 1850. Existují totiž mnohem starší zprávy o lidech s nemocemi, které měly podobné příznaky, jaké byly později popsány u pacientů s leukemiemi.
Leukemie by nebyla objevena bez objevu mikroskopu. Mikroskop byl v 19. století stále ještě nedokonalý přístroj, a proto je pozoruhodné, že nemoc již tehdy rozpoznána byla. V té době byly navíc velkým problémem medicíny zejména časté epidemie infekčních chorob. Hnisání (což je hromadění bílých krvinek) při infekčních chorobách bylo často s leukemiemi mylně zaměňováno.
V posledních letech 19. století byl objeven význam kostní dřeně pro krvetvorbu. Díky zdokonalení mikroskopu bylo možno rozeznat jednotlivé typy bílých krvinek. Tak začala nová éra hematologie (vědy o krvetvorbě a jejích chorobách).
První léky, které byly účinné v léčbě leukemií, pomineme-li arzenik používaný od 2. poloviny 19. století, se objevily po roce 1950. Transplantace kostní dřeně se začaly provádět v 60. letech 20. století, většího rozmachu se ale dočkaly až po roce 1980. V poslední době se do terapie leukemií dostávají i léky, které nemají charakter cytostatik.
Co je to kostní dřeň, krev a jaké jsou jejich funkce v lidském těle?
Kostní dřeň je houbovitá tkáň vyplňující dutiny kostí. V dospělosti ji dělíme na kostní dřeň červenou (produkuje krevní buňky) a žlutou (tukovou).
Červená kostní dřeň se nachází v plochých kostech, hrudní kosti, kostech klíčních, obratlích, kostech pánevních a dlouhých kostech končetin.
Funkcí kostní dřeně je především tvorba krevních buněk (krvinek) tak, aby lidský organismus netrpěl jejich nedostatkem. Kostní dřeň zajišťuje rovnoměrné zastoupení jednotlivých typů krevních buněk v krvi. Krevní buňky vznikají z kmenových zárodečných buněk, které obsahuje právě kostní dřeň. Z kmenových buněk vznikají tři hlavní typy krvinek - červené krvinky, bílé krvinky a krevní destičky. Tyto tři typy krevních buněk spolu s krevní plazmou (čirou tekutinou nažloutlé barvy) a krevními bílkovinami tvoří krev.
Funkcí krve je přenos krevních plynů, živin, vitamínů, tepla, odpadních látek a obrana organizmu proti infekci.
Hlavními typy krevních buněk jsou:
- červené krvinky (erytrocyty) - obsahují červené krevní barvivo (hemoglobin) a zajišťují přenos kyslíku z plic do tkání,
- krevní destičky (trombocyty) - jsou nejmenšími z krevních buněk a podílí se v součinnosti s dalšími složkami krve na krevním srážení (hemostáze, koagulaci),
- bílé krvinky (leukocyty) - jsou součástí imunitního systému, který chrání organizmus před působením choroboplodných zárodků zevního prostředí. Rozlišujeme několik typů bílých krvinek:
- lymfocyty (B, T a NK buňky) - produkují protilátky a podílí se velkou měrou na ochraně organismu před virovou infekcí,
- granulocyty (neutrofily, bazofily, eozinofily) - představují první linii ochrany organizmu před nejrůznějšími infekcemi (včetně bakteriálních a parazitárních),
- monocyty - brání tělo před infekcemi a ničí a odstraňují poškozené nebo mrtvé buňky a choroboplodné zárodky.
Co je to lymfatický systém a jaké jsou jeho funkce?
Lymfatický systém je soustava lymfatických orgánů a lymfatických cév, které prostupují všemi tkáněmi lidského těla a spojují je s lymfatickými orgány. Mezi lymfatické orgány patří brzlík (tymus, v dospělosti mizí), kostní dřeň, slezina, lymfatické (mízní) uzliny, krční, nosní a patrové mandle a shluky lymfatické tkáně, která je součástí trávícího a dýchacího ústrojí. Převažujícím typem buněk, ze kterých se lymfatický sytém skládá, jsou bílé krvinky zvané lymfocyty.
![]() Obrázek 2. Oblasti mízních uzlin těle. |
Lymfatickými cévami proudí míza (lymfa) - bezbarvá až mléčně zbarvená tekutina, která vzniká v mezibuněčných prostorech tkání z tkáňového moku. Do průběhu mízních cév jsou na určitých místech uloženy mízní uzliny, kterými všechna lymfa protéká a "čistí" se v nich. Lymfatické uzliny se vyskytují ve větších skupinách v určitých oblastech lidského těla. Hlavními místy jejich nakupení jsou oblasti krku, podpaží, třísla, dutina břišní, kde jsou podél velkých cév, mezihrudí a okolí páteře. Viz obrázek 2. Lymfatické uzliny mohou být hmatné i u zdravého člověka – jejich velikost ale u zdravých nepřesahuje 1 – 1,5 cm. K jejich zvětšení dochází nejčastěji při infekcích nebo nádorových onemocněních. Jedním z onemocnění, které mnohdy způsobuje výrazné zvětšení lymfatických uzlin jsou i některé leukemie (zejména chronická lymfocytární leukemie).
Lymfatický systém zajišťuje zpětný transport vody a odpadních látek z tkání zpět do krve a jako součást imunitního systému se podílí na obraně lidského těla proti infekčním i neinfekčním nemocem. V lymfatických uzlinách také probíhá konečná fáze zrání B lymfocytů, které tvoří protilátky proti nejrůznějším antigenům (látky kolem nás, které jsou cizí našemu tělu) ze zevního prostředí. V uzlinách se lymfocyty setkávají s antigeny.
Co to vlastně je leukemie?
Leukemie ("bělokrevnost") je skupina onemocnění, které se projevují nádorovým zmnožením určitých skupin bílých krvinek v kostní dřeni a většinou i v krvi. Jde o nemoci zhoubné povahy, i když jejich zhoubnost je u různých typů leukemií různá (od málo zhoubných variant leukemie po vysoce agresivní nemoci). Zhoubnost leukemií spočívá v tom, že zmnožené "špatné" bílé krvinky nevykonávají svou obrannou funkci a naopak utlačují zdravé krvetvorné i jiné buňky v lidském těle.
Jaké jsou typy leukemií?
Jak už bylo řečeno, leukemií je více. Jednoduše lze říct, že leukemie jsou akutní (většinou probíhají rychle a mohou nemocného zahubit během dnů nebo týdnů od svého vzniku) nebo chronické (probíhají pomaleji a někdy dokonce měsíce i roky nevyžadují žádnou léčbu). Dále lze leukemie dělit podle typů bílých krvinek, z nichž vznikají.
Leukemie se podle typu zmnožených krvinek rozdělují do mnoha druhů. Většinou ale pro běžnou komunikaci stačí rozdělení na 4 hlavní typy. Leukemie může být označena jako myeloidní, pokud postihuje tvorbu monocytů či granulocytů, či jako lymfatická, pokud postihuje tvorbu lymfocytů. Spojíme-li toto dělení s dělením leukemií na akutní a chronické, dobereme se k těmto typům nemoci: akutní myeloidní leukemie (AML), akutní lymfatická leukemie (ALL), chronická myeloidní leukemie (CML) a chronická lymfocytární leukemie (CLL). Akutní formy leukemií mají rychlý průběh a neléčeny vedou velmi rychle ke smrti nemocného. Chronické formy mají pomalý a postupný průběh a nemocný může žít i několik let bez léčby, než je choroba rozpoznána. U akutních leukemií jsou výrazně zmnoženy jedny z nejmladších buněk vývojové řady - blasty (obrázky 3 a 4), zatímco u chronických leukemií dochází ke zmnožení zralejších buněk, které však nemají normální funkci (obrázky 5 a 6).
![]() Obrázek 3. Blasty akutní lymfatické leukemie. |
![]() Obrázek 4. Blasty akutní myeloidní leukemie. |
![]() Obrázek 5. Buňky chronické lymfatické leukemie (malé tmavé buňky). |
![]() Obrázek 6. Buňky chronické myeloidní leukemie. |
Jak se leukemie projevují?
![]() Obrázek 7. Zbytnění dásní u pacienta s akutní leukemií. |
Leukemie nemají žádný zcela typický příznak, podle nějž by je nemocný i lékař snadno poznali. Zmnožení rakovinných bílých krvinek vede k úbytku zdravých bílých krvinek, krvinek červených a krevních destiček. Zmnožení zhoubných bílých krvinek může způsobit to, že se tyto krvinky kupí v různých orgánech, které se zvětšují. Leukemie se tak může projevit především nebolestivým zvětšením lymfatických (mízních) uzlin na krku, v podpaždí nebo v tříslech, může se projevit zvětšením sleziny (nemocného může pobolívat břicho v levém podžebří) nebo jater. Toto zvětšování uzlin nebo sleziny probíhá většinou plíživě, ne ze dne na den, a nemocný jim nemusí velmi dlouho věnovat pozornost. Někdy je přítomno zbytnění dásní (obrázek 7). Úbytek zdravých bílých krvinek způsobuje snížení obranyschopnosti: leukemie se tak může projevit jako infekce, někdy připomínající banální onemocnění s chřipkovými příznaky, jindy probíhající třeba jako těžký a nenadále vzniklý zápal plic. Úbytek červených krvinek způsobuje ztrátu tělesné výkonnosti, nemocní se při námaze zadýchávají, snadno se unaví, mohou cítit bušení srdce nebo se jim motá hlava. Pokud je ale úbytek červených krvinek pozvolný, nemusí jej nemocný velmi dlouho vůbec vnímat a tělo si na něj (i když jde o úbytek až poloviny nebo dokonce dvou třetin červených krvinek) zvykne. Závažný úbytek krevních destiček může způsobit krvácení - nejčastěji krvácení z nosu, dásní, nezastavitelné krvácení po vytržení zubu nebo kožní tečkovité a splývavé krvácení (obrázek 8). Kromě toho leukemické buňky často produkují látky, které samy o sobě způsobují horečku, poškozují vnitřní orgány (ledviny, játra, plíce) a ovlivňují faktory krevní srážlivosti. U mnoha nemocných se na nemoc přijde náhodně (při preventivní prohlídce, při předoperačním vyšetření) ve stádiu, kdy se nemoc nijak neprojevuje, u některých pacientů se bohužel i dnes na nemoc přijde pozdě, ve chvíli, kdy už jim nelze pomoci. Z toho plyne jediné ponaučení: všechny netypické či déle trvající
![]() Obrázek 8. Tečkovité krvácení v kůži bérců u nemocného s leukemií (petechie) a větší splývavé krvácení (ekchymózy). |
banální příznaky (teplota, nachlazení, nepatrné krvácení, únava, zadýchávání, pobolívání břicha v podžebří) není dobré podceňovat a je vhodné provést vyšetření krve - tzv. krevní obraz. U 9 z 10 nemocných se potvrdí, že jde o banalitu, ale u jednoho nemocného se včas přijde na vážnou nemoc.
K celkovým projevům leukemií někdy patří:
- horečka nad 38 C,
- noční pocení - často s nezbytnou výměnou prádla,
- větší úbytek hmotnosti (více jak 10% hmotnosti za půl roku),
- celková slabost, únavnost, dušnost, bledost, bušení srdce, hučení v uších nebo bolesti na hrudi (projevy nedostatku červeného krevního barviva při nedostatečné tvorbě červených krvinek).
Leukemické buňky někdy představují významnou masu buněk. Může jít i o kilogramy nádoru, který "plave" v krvi. Viz obrázek 9.

Obrázek 9. Vak s leukemickými buňkami po jejich odběru z krve metodou tzv. leukaferézy. Silná bílá vrstva mezi vrstvou červenou (červené krvinky) a žlutou (krevní plazma) představuje masu leukemických bílých krvinek.
Jak leukemie vznikají a lze jim předejít?
Otázka příčin leukemií a výskytu těchto nemocí je velmi složitá. Tak například běloši mívají velmi často chronickou lymfocytární leukemii, kterou daleko méně trpí jiná etnika a kterou asi nezapříčiňují nebo nespouštějí žádné zevní vlivy. Akutní lymfatická leukemie u dětí je častá v bohatých zemích Evropy a severní Ameriky a téměř se nevyskytuje v zemích chudých. Mnoho leukemií lze vyvolat ozářením. Také některé látky je mohou způsobovat – například chemoterapie. Příčin leukemií je mnoho a málokterou z nich bohužel stále přesně známe, i když poznatky o tak zvané molekulární patogenezi onemocnění rychle přibývají. Objevují se například důkazy o tom, že akutní lymfoblastické leukemie nebo akutní myeloidní leukemie mohou mít příčiny ve vrozené genetické predispozici. Rozhodně ale nejde o většinu leukemií.
Co v dělat v prevenci leukemií? Obecně zde platí, že každý z nás by se měl vyvarovat stresu, měl by mít fyzickou aktivitu, neměl by kouřit. Bohužel žádný konkrétní recept na to, jak se leukemii vyvarovat neexistuje.
U mnohých leukemií se v nádorových bílých krvinkách najdou změny genetické výbavy těchto buněk, které ale nejsou vrozené a dědičné, ale které se v nich objevily až v průběhu pacientova života. Tyto změny mohou být pro některé z nemocí typické a lze podle nich diagnózu nemoci upřesnit nebo je podle nich (jejich úbytku) možné sledovat účinnost terapie.
Jak se stanovuje diagnóza leukemie?
Pro stanovení diagnózy leukemie je nutné provést řadu vyšetření. Nejjednodušším a základním vyšetřením je laboratorní vyšetření vzorku krve - krevní obraz.
Dalšími vyšetřeními jsou vyšetření krve na speciálním přístroji - průtokovém cytometru, který je schopen detekovat typické znaky nádorových buněk leukemií, které se nacházejí na jejich povrchu.
Nezbytnou součástí stanovení diagnózy leukemie je vyšetření kostní dřeně. Odebírá se malý vzorek kostní dřeně z lopaty kosti kyčelní (oblast hýždě) nebo častěji se nasává kostní dřeňová krev z kosti hrudní (sternální punkce). Tento zákrok je prováděn ambulantně v místním znecitlivění, po kterém je do kosti zavedena speciální jehla. Vzorek kostní dřeně bývá je odesílán na cytologické a případně histologické vyšetření. Nezbytnými vyšetřeními se v současnosti stávají cytogenetické a molekulárně genetické vyšetření nádorových buněk, která zpřesňují prognózu nemocných.
Ultrazvukové vyšetření dutiny břišní je vyšetřením, které umožní pomocí speciální sondy, pracující na principu odrazu ultrazvukových vln jednotlivými tkáněmi lidského těla, posoudit orientačně stav jater, sleziny, uzlinových oblastí a dalších orgánů, které mohou být při onemocnění chronickou lymfatickou leukemií postiženy.
CT (počítačová tomografie) vyšetření hrudníku, břicha a pánve, je podrobným vyšetřením využívajícím podobně jako klasické rentgenové vyšetření rentgenového záření. Obrazy získané tímto vyšetřením jsou zpracovány počítačem, který umožňuje prostorové zobrazení vnitřních orgánů a dokonalejší posouzení jejich stavu a možného postižení.
Výše uvedená vyšetření patří mezi standardně prováděná vyšetření při podezření na onemocnění především chronickými leukemiemi. Před zahájením vlastní léčby mohou být provedena na doporučení ošetřujícího lékaře podle celkového klinického stavu nemocného ještě vyšetření další (vyšetření srdce, funkce plic, cukrovky atd.)
Jak se leukemie léčí?
Zdraví a nemoc určitě představují dva rozdílné světy. Jeden je známý, druhý, pro člověka, jenž právě onemocněl, ještě neznámý. Hranice mezi těmito světy bývá ale často velmi tenká, tenčí, než si mnozí uvědomují. Každý z nás může tuto hranici kdykoliv překročit a každý z nás by asi zprvu to, že se ocitl někde na druhém břehu, vnímal jako nespravedlnost, trest, jako zoufalství, ztrátu, litoval by se, měl by vztek na zdravé lidi a možná i na doktory, kteří mu jeho nemoc zjistili, sdělili mu diagnózu a zavřeli jej do nehostinné nemocnice. Po prvotním šoku se ale většina nemocných rozhodne nepřízni osudu vzepřít a zjistí, že nemoc nepředstavuje svět, z nějž není návratu, který je natrvalo jiný, než svět zdravých. Sílu postavit se chorobě si dodávají navzájem s dalšími nemocnými. Společný úděl nemocné samozřejmě sbližuje.
Leukemie jsou nádorová onemocnění, která je v současné době dobře léčitelná a často plně vyléčitelná. Mnohdy se ani léčit nemusí (nepokročilá stádia chronické lymfocytární leukemie, vlasatobuněčná leukemie). Dobře zvolenou a vedenou léčbou je možné pacientům zajistit kvalitní a po všech stránkách plnohodnotný život.
Základem léčby akutních leukemií je stále chemoterapie, která se ale kombinuje i s léky, které nejsou chemoterapeutiky. Tyto tak zvané biologické léky se již dostaly mnohem výrazněji do léčby chronických leukemií. Jsou to například protilátky proti nádorovým buňkám a léky, které zasahují pouze nádorové buňky v místě jejich chybné genetické změny, nebo další látky ze skupin tzv. biologické léčby (inhibitory kinázy bcr-abl u chronické myeloidní leukemie, či inhibitory BCR signalizace u chronické lymfocytární leukemie). Radioterapie je dnes používána jen ojediněle.
Transplatace kostní dřeně od dárce (příbuzného nebo nepříbuzného) je standardní metodou léčby některých leukemií, ale obecně lze říct, že se transplantuje a musí se transplantovat menšina pacientů.
Kromě výše uvedených léčebných postupů, které se většinou řadí mezi postupy kurativní (chceme nemoc vyléčit), jsou i léčebné postupy paliativní (léčíme onemocnění, aby nedělalo nemocnému potíže, ale nesnažíme se nemoc vyléčit) a symptomatické (léčí se jen příznaky nemoci).
Jaké jsou léčebné postupy?
Lidí, kteří měli nebo mají leukemii, přibývá. Tak zvaná prevalence leukemií vzrostla za posledních 20 let trojnásobně. A to je dobrá zpráva. Tohle konstatování není cynismus. Těchto lidí celosvětově přibývá, protože je umíme lépe léčit, protože je umíme mnohdy i vyléčit. Ještě před nedávnem téměř všichni nemocní s agresivnějšími leukemiemi záhy umírali. Dnes už tak tomu není. Nyní máme více prostředků, které nám umožňují leukemie včas zjistit. Dříve mohlo mnoho nemocných zemřít, aniž bychom vůbec věděli, že leukemií trpěli.
Spoustu nemocných s leukemií lze vyléčit. Existují i leukemie, které léčit vůbec nemusíme. Některé druhy leukemií lze vyléčit skoro u každého nemocného (samozřejmě za předpokladu, že je léčba zahájena včas). Jde například o akutní lymfoblastickou leukemii u dětí, o akutní promyelocytární leukemii nebo o tzv. vlasatobuněčnou leukemii. Bohužel na druhé straně stále existují leukemie, které lze vyléčit jen u některých pacientů, nebo které nelze vyléčit vůbec. Je dokonce prokázáno, že u velmi starých lidí s akutními leukemiemi agresivní léčba, která zachraňuje mladší nemocné, starým lidem život zkracuje a zhoršuje jeho kvalitu ve srovnání s tím, když je agresivně neléčíme. V současnosti lze už dopředu podle nejrůznějších vlastností leukemických buněk odhadnout, jak se nemoc bude chovat a jak agresivní musí být náš postup, abychom nemocného vyléčili nebo mu dali co největší naději na vyléčení.
Nových léků pro pacienty s leukemiemi je stále víc. Potíží ale je, že tyto nové léky jsou čím dál dražší a že i v mnoha ekonomicky vyspělejších zemích než je ta naše se o narůstající ceně léčby vážně diskutuje. Léčba jednoho nemocného s leukemií nezřídka stojí ročně více než milion korun (a je to léčba trvající mnohdy roky). Cena jedné transplantace kostní dřeně se pohybuje od jednoho milionu do více než 10 milionů korun, má-li nemocný po transplantaci nějaké komplikace. Hlavní podíl na rostoucí ceně léčby nemocných s leukemiemi mají léky.
Chemoterapie je jednou ze základních možností léčby zejména akutních leukemií. Jejím principem je podávání syntetických látek, kterým říkáme cytostatika, tedy léků, které zastavují buněčný růst. Tyto léky jsou podávány ve formě tablet, nitrožilních injekcí a infůzí. Látky takto podané se dostávají krevním oběhem do všech tkání lidského těla ničí zde nádorové buňky. Cytostatika používaná při chemoterapii nejsou bohužel specifická pouze pro nádorové buňky, ale poškozují (přechodně) i zdravé buňky tkání. Z tohoto poškození zdravé tkáně plynou i nežádoucí účinky chemoterapie. Principem chemoterapie je tedy zničení populace nádorových buněk v těle pacienta za cenu co nejmenšího poškození zdravých tkání.
Nežádoucí účinky chemoterapie se liší v závislosti na typu a dávce užitého cytostatika. Pro zvýšení účinku cytostatik a zároveň snížení intenzity nežádoucích projevů léčby se ve většině případů používá kombinace více cytostatik. Jedná se tedy o kombinovanou cytostatickou léčbu.
Chemoterapie bývá podávána ve většině případů v určitých časových intervalech, kterým říkáme cykly (období mezi dvěma podáními chemoterapie). Toto období umožňuje vyloučení cytostatik z pacientova těla a regeneraci organismu tak, aby byl schopen podstoupit další léčbu. Podle typu a dávky užitých cytostatik v kombinované léčbě je chemoterapie podávána ambulantně (méně agresivní cytostatické léčebné režimy) nebo za hospitalizace.
K nejčastějším nežádoucím účinkům chemoterapie patří:
- nevolnost, zvracení, průjmy, nadýmání a další zažívací obtíže - současná medicína však nabízí širokou škálu léků, které těmto nežádoucím účinkům zabrání nebo je minimalizují,
- vypadávání vlasů a ochlupení - jedná se pouze o přechodný stav, jehož intenzita závisí na typu použitých cytostatik, po vysazení chemoterapie se růst vlasů a chlupů upraví,
- poškození sliznic (mukozitida) - buňky trávícího ústrojí od dutiny ústní až po konečník jsou podobně jako buňky nádorové velmi vnímavě k podání cytostatik, která je poškodí, což se může projevit obtížemi při polykání, afty, bolestí v ústech, průjmem, bolestmi při odchodu stolice,
- infekční komplikace - častým a nejvíce rizikovým nežádoucím účinkem léčby cytostatiky, který je způsoben přechodným nedostatkem bílých krvinek (leukocytů) a poruchou jejich funkce v období několika dnů až týdnů po podání chemoterapie,
- poškození krvetvorby - jeho projevem je nedostatek funkčních krvinek v krvi, jedná se zvláště o nedostatek červených krvinek (erytrocytů), který způsobuje tzv. anemický syndrom (únava, slabost, bušení na hrudi, bledost, dušnost, hučení v uších aj.) a dále nedostatkem krevních destiček (trombocytů) a s tím spojené zvýšené riziko krvácení. Při poklesu červených krvinek a krevních destiček pod kritickou mez může být přistoupeno k podání krevních transfuzí.
Radioterapie je léčebnou metodou, která využívá ionizujícího záření zastavující růst nádorových buněk. V léčbě leukemií je doplňkovou metodou. Využívána je zejména při extrémním zvětšení sleziny a uzlin, které působí mechanické obtíže, nebo obtíže funkčního rázu. Radioterapie je dále součástí některých transplantačních režimů.
Kortikoterapie, podávání léků jako prednizon, metylprednizolon nebo dexametazon, se používá v případech tvorby abnormálních protilátek namířených proti vlastnímu tělu nemocného (autoprotilátek), protilátek, které napadají složky krve nebo jiné orgány.
Imunoterapie je moderní léčebnou metodou využívající schopností vlastního imunitního systému v ničení nádorových buněk. V současné době je v léčebné praxi užíváno několik protilátek namířených proti nádorovým buňkám (např. rituximab, obinotuzumab, blinatumomab nebo alemtuzumab), mnohé další do medicínské praxe jistě brzy vystoupí nebo jsou objektem intenzivního vědeckého bádání. Protilátky jsou v léčbě chronické lymfatické leukemie používány samostatně nebo jako součást kombinované chemoterapie, jejíž účinky podporují.
Necytostatická léčba ovlivňuje pouze nádorové buňky. U pacientů s chronickou myeloidní leukemií se podává lék imatinib, který selektivně blokuje bílkovinu (kinázu bcr-abl), která je produktem genetické změny v nádorových buňkách. Podobně působí i dasatinib nebo nilotinob. U chronické lymfocytární leukemie se začíbají používat inhibitory BCR signalizace (ibrutinib, idelalisib), nebo inhibitory proteinu Bcl-2 (venetoklax)
Transplantace krvetvorné tkáně (kostní dřeně) je metodou, při níž je krvetvorba nemocného nahrazena krvetvorbou dárce (sourozence, nepříbuzného dárce), nebo krvetvorbou vlastní, která byla před vysokodávkovanou terapií odebrána.
Transplantační léčba je prováděna jen na specializovaných pracovištích, která jsou dostatečně technicky vybavena, a která mají s tímto typem léčby dostatek zkušeností.
Principem transplantace krvetvorné tkáně je možnost použití intenzivnější a agresivnější chemoterapie, která má větší účinek na nádorové onemocnění, která však kromě výše uvedeného efektu také zásadním způsobem poškozuje krvetvorbu pacientova organismu a v konečném důsledku vede až k jejímu úplnému zničení.
Převod krvetvorné tkáně, který je prováděn formou nitrožilní infuze nám umožňuje ztracenou krvetvorbu obnovit. Podle typu převáděné krvetvorné tkáně rozeznáváme transplantaci kostní dřeně a transplantaci periferních kmenových buněk (nezralých buněk, které jsou obsaženy v kostní dřeni, a které dávají vzniknout všem krevním buňkám; získávány jsou od dárce po předchozím podání tzv. stimulační chemoterapie následované podkožním podáním růstových faktorů; vlastní sběr je prováděn žilní linkou pomocí přístroje zvaného separátor).
Podle zdroje krvetvorné tkáně dělíme transplantaci na:
- autologní - dárcem krvetvorné tkáně je sám pacient,
- alogenní - dárcem krvetvorné tkáně je pacientův příbuzný (nejčastěji sourozenec) nebo cizí dárce vybraný podle přesně stanovených kritérií z registru dárců kostní dřeně,
- syngenní - dárcem je jednovaječné dvojče pacienta.
Vlastní transplantace probíhá na speciálně upravených transplantačních pokojích - v tzv. life islands (ostrovech života). Pacientovi je podána vysokodávkovaná chemoterapie v průběhu několika dní před vlastní transplantací, která je provedena formou nitrožilní infuze štěpu krvetvorné tkáně. V prvních několika potransplantačních dnech dochází k významnému poklesu počtu červených a bílých krvinek a krevních destiček. Červené krvinky a krevní destičky musí být často doplněny formou transfuzí. Nedostatek bílých krvinek se projeví zvýšeným rizikem infekčních komplikací, které musí být řešeny pomocí antibiotik. V průběhu několika dnů až týdnů dojde k postupnému uchycení štěpu a obnově vlastní krvetvorby. U nemocných s chronickou lymfatickou leukemií by měla být zvažována především transplantace alogenní nebo syngenní.
V České republice existují dva registry dárců kostní dřeně: Český registr dárců kostní dřeně se sídlem v Praze a Český národní registr dárců kostní dřeně se sídlem v Plzni. Oba tyto registry spolu spolupracují. A stejně tak spolupracují i s registry zahraničními. Bez vzájemné spolupráce registrů by bylo nalezení vhodného nepříbuzného dárce pro nemocné, u nichž je transplantace krvetvorných buněk od nepříbuzného dárce jedinou nadějí na vyléčení, velmi komplikované. Pokud by se někdo rád stal dárcem kostní dřeně, respektive byl evidován v registru dárců, poučí jej o této možnosti na každé transfúzní stanici v naší zemi. Kritéria pro zařazení do registru dárců dřeně nebo krvetvorných buněk jsou podobná jako kritéria pro dárcovství krve.
A jak je to s pravděpodobností nalezení vhodného dárce kostní dřeně? Pokud má někdo z nemocných jednovaječné dvojče, pak toto dvojče je pro něj jistým dárcem kostní dřeně. Jestliže hledáme dárce dřeně mezi vlastními sourozenci nemocného, pak pravděpodobnost, že si dva vlastní sourozenci mohou darovat kostní dřeň, je asi čtvrtinová. Pravděpodobnost, že se najde dárce kostní dřeně u dalších příbuzných (rodičů, dětí, bratranců, sestřenic, strýců a tet) je o mnoho menší. Pravděpodobnost, že se najde dárce kostní dřeně mezi nepříbuznými osobami je asi jedna ku jednomu nebo dvěma milionům. Na světě je ale evidováno přes osm milionů dárců, zejména bělochů. Proto pravděpodobnost, že najdeme dárce kostní dřeně v registrech dárců pro nemocného pacienta - bělocha, je velmi vysoká. Kromě registrů dárců kostní dřeně existují i tak zvané banky pupečníkové krve. Jedna funguje také v České republice. V těchto bankách se uchovává pupečníková krev narozených dětí, krev z placenty. V pupečníkové krvi je totiž velké množství krvetvorných buněk, které lze za určitých okolností použít k transplantaci.
(Redakční poznámka: více o transplantaci krvetvorných buněk najdete v článku od prof. MUDr. Michael Doubek, PhD. s názvem Transplantace krvetvorných buněk v části léčba)
Co se děje po ukončení léčby?
I když je nemocný s leukemií vyléčen, zůstává pravidelně sledován na specializovaném hematologickém pracovišti. To proto, aby se včas zachytily pozdější komplikace terapie nebo aby se včas zjistil přece jen možný návrat onemocnění.
Co když se leukemie vrátí?
Leukemie se bohužel může i po úspěšné terapii vrátit. A to někdy i za několik let po skončení terapie. To neznamená, že by ale už nešla léčit a vyléčit. Pro tyto případy jsou k dispozici speciální léčebné protokoly.
Kde mohu najít další informace?
Další informace lze získat v publikacích, o nichž je zmínka v jiné sekci stránek České onkologické společnosti. Dále se lze informovat na www stránkách České leukemické studijní skupiny pro život, České skupiny pro chronickou lymfatickou leukemii, Interní hematoonkologické kliniky LF MU a FN Brno či na stránkách sdružení pacientů s leukemiemi nebo lymfomy.